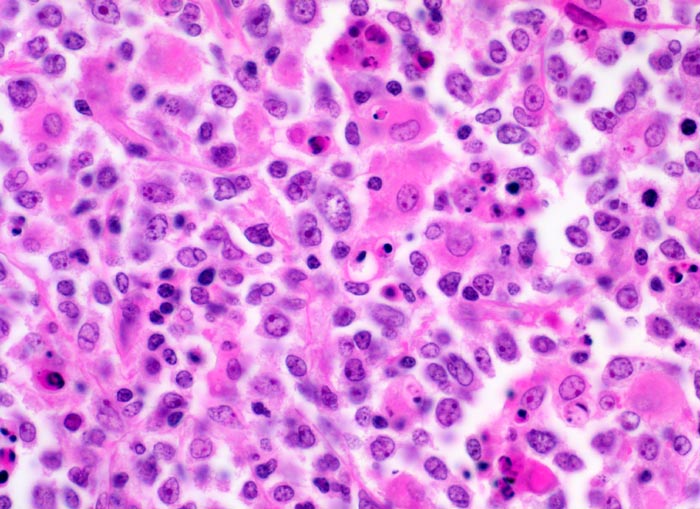

PathoPic – image database / PathoPic ID 3933 - Diffuses grosszelliges B-Zell Lymphom
de
Diagnose
Diffuses grosszelliges B-Zell Lymphom
Diagnose Gruppe
maligner Tumor
Topographie
Lymphknoten, abdominal
Topographie Gruppe
Lymphatische Gewebe, KM, Milz
Beschreibung
Mittelgrosse polymorphe Tumorzellen mit unregelmässig geformten, teils lobulierten Kernen. Gelegentlich sind mehrere randständige Nukleolen erkennbar (Zentroblastische Variante). Schmaler Zytoplasmasaum. Neben den Tumorzellen sind zahlreiche Histiozyten mit reichlich eosinophilem Zytoplasma und ovalen Kernen ohne Atypien nachweisbar. Das Zytoplasma der Histiozyten enthält teilweise phagozytierte Zelltrümmer.
Klinik
Magenlymphom mit Befall abdominaler Lymphknoten.
Bilder Typ
Histologie
Vergrösserung
400
Alter
52
Geschlecht
männlich
Datum
Ersteintrag: 28.09.2002
Update: 04.02.2024